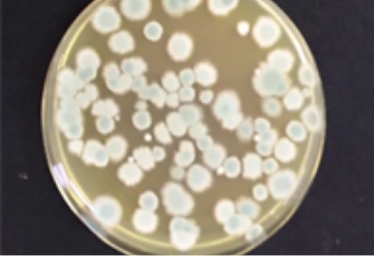
ハニカム付着ホコリカビ・菌​​​​​​​

ABOUT
冷蔵ショーケースのハニカムを、
清潔に保つための防塵シート
ハニカム防塵シートは、冷蔵ショーケースの上部に設置されている「ハニカム部分」専用の清潔・清掃サポートシートです。
清掃が行き届きにくく、カビやホコリが溜まりやすいハニカムに取り付けることで、汚れの付着を抑え、清潔な状態を保ちやすくします。
専門的な清掃作業に頼らず、店舗スタッフの方でも簡単に交換できることを前提に設計されています。
の特長
FEATURES
カビや汚れの付着を抑え、衛生状態を保つ
ハニカム防塵シートは、ホコリや汚れをシート側でキャッチする構造です。
撥水素材を採用することで、カビや菌の繁殖を抑制し、ハニカム本体が不衛生な状態になるのを防ぎます。見えにくい場所だからこそ、「汚れにくい状態をつくる」という考え方で衛生管理をサポートします。

冷却効率の低下を防ぎ、省エネにも貢献
ハニカムにホコリが溜まると、冷気の流れが乱れ、冷蔵ショーケースの冷却効率が低下します。ハニカム防塵シートを設置し、定期的にシート交換を行うことで目詰まりを防止。結果として、冷却効率を保ち、電力消費の増加を抑える効果が期待できます。
清掃作業を減らし、現場の負担を軽減
従来のハニカム清掃は、取り外し・洗浄・乾燥・再設置といった工程が必要で、時間と人手がかかる作業でした。ハニカム防塵シートなら、汚れたシートを交換するだけ。清掃にかかる手間と作業時間を大幅に軽減できます。
を設置しておけば楽々!!
EASY TO USE
ハニカム防塵シートを装着しておけば、定期清掃での作業もスピーディー。
防塵シート未使用状態

▶
防塵シートでハニカムはキレイ


シートは定期的に目視チェックして
適宜交換しましょう
・店舗のロケーションや床の清掃状態、冷蔵ショーケースの設置位置によって、ハニカム防塵シートの汚れ具合には差が生じます
・新品または洗浄し機能回復したハニカムに防塵シートを貼り、定期的に交換する事でホコリの付着防止と省エネ&不衛生状態の改善が図れます。
の交換方法
HOW TO USE
ハニカム防塵シートを装着しておけば、定期清掃での作業もスピーディー。
約5〜7分/冷蔵ケース1台
STEP
01

ハニカムを
取り外す
▶
STEP
02

汚れたシートを
取り外す
▶
STEP
03

新品のシートを
設置
▶
STEP
04

シートを金具で
取り付け
▶
STEP
05

ハニカムの
取り付け
店舗スタッフの方でも対応でき、日常業務の中で無理なく交換が可能です。
商品ラインナップ
ハニカム
防塵シート
PE24シート





形状
シート
シート
シート
シート
シート
幅
50mm
70mm
80mm
90mm
100mm
長さ
900mm
1200mm
900mm
1200mm
900mm
1200mm
900mm
1200mm
900mm
1200mm
品番
PE24-50×900
PE24-50×1200
PE24-70×900
PE24-70×1200
PE24-80×900
PE24-80×1200
PE24-90×900
PE24-90×1200
PE24-100×900
PE24-100×1200
参考価格
(税別)
お問い合わせください
お問い合わせください
お問い合わせください
お問い合わせください
お問い合わせください
ハニカム
防塵シート
PE24ロール





形状
ロール
ロール
ロール
ロール
ロール
幅
50mm
70mm
80mm
90mm
100mm
長さ
48m
48m
48m
48m
48m
品番
PE24-R50
PE24-R70
PE24-R80
PE24-R90
PE24-R100
参考価格
(税別)
お問い合わせください
お問い合わせください
お問い合わせください
お問い合わせください
お問い合わせください
CONTACT
冷蔵ショーケースの「清掃・カビ対策」を、もっと簡単に。
清掃し続けるしかなかった冷蔵ショーケースのカビ対策を、
「設置するだけ」の新しい方法へ。
ハニカム防塵シートが、清潔で安心な売場づくりを支えます。
社会的背景(食の安心安全)
2021年6月1日 HACCP(ハサップ)導入が義務化された事により、
食品・食材提供を生業とする全ての事業者は、入荷・保管・加工・包装・陳列等
あらゆる角度から衛生管理体制を一層整備する事が求められる事になりました。
見えない食品販売店の問題点
日本国内には250万台以上の冷蔵ショーケースが設置されていますが、
適切な管理、清掃が行き届いていないハニカムが多数存在しているのが現状です。

ドラッグストア

スーパーマーケット

生協

コンビニエンスストア
ハニカム付着ホコリカビ・菌

ホコリが蓄積しカビが繁殖
極めて不衛生なハニカム
省エネの観点からのハニカム清掃
電気料金の高騰は、今後も企業収益を益々圧迫して行きます。
ハニカムが綿ボコリなどで目詰まりしますとエアカーテンの力が落ち、 冷却能力が落ちると共に消費電力が年間5~10%増加します。
またショーケース天井部に水滴がつきやすくなり陳列商品に影響をおよぼすこともあります。
電気料金の節約の為、半年に1回の割合で定期的に清掃してください。
コメント・画像:冷ケース・メーカーHPより
清潔なハニカムの店舗は、目詰まり状態の店舗に比べ
年間80~100万円の電気代削減が期待できます。
● 50~60台の冷ケース設置店舗の場合
● 電力単価 25円/Kwhで試算
消費電力量の実測テスト
実際に比べてみました
ホコリで目詰まりしたハニカムを清掃して冷気の流れを回復すると、
消費電力量低減に効果があるかを、同規模の清掃実施店・未実施店で比較してみました。
1.データ計測結果
A店
B店

ハニカム清掃+防塵シート設置

汚れたままのハニカム
ショーケース設置台数
50台
52台
使用電力量
(kwh)
2016年 8月
63,681
65,131
2017年 9月
55,843
62,330
削減量
7,838
2,801
削減率
12.3%
4.3%
注1) B店の前年比4.3%電力量減少については、年ごとの気象の影響と推定
注2) 電力単価 25円/kwh で算出
2.節電効果
清掃+シート設置の
節電効果
8%
約 70,000円/月
A店とB店の差
12.3-4.3=8%
店舗の節電量の
冷蔵ショーケース分
3.業界の「節電目安」は6%
ハニカムの清掃を怠り、汚れの蓄積が顕著な場合は増エネ(消費電気量の増大)を招きます。
国内の冷蔵ショーケースメーカー各社は定期的なハニカム清掃を推奨しています。
目安として定期清掃を実施した場合、放置したままに対して概ね6%(5-10%)の節電効果としています。


長年に渡り付着したホコリを洗浄した画像です。若干の色見は残りますがハニカム本来の機能を回復し、冷気はスムーズに整流回復しました。
「消費電力量削減=CO2削減」による社会貢献

SDGs (持続可能な開発目標) とは
「誰1人取り残さない」という理念のもと、持続可能な社会を実現するために国連で採択された、2030年までに世界が取り組むことが求められている目標です。
▼1店舗で80万円の年間電気代を削減することは
⇒ CO2を25,104kg 排出削減する事にリンクします。
※ 50台の冷蔵ショーケース設置した店舗の場合
▼運営店舗数を80店舗と仮定した場合
⇒ 6,400万円の年間電気代削減
⇒ CO2は2,000㌧(2,008,320kg)排出削減
となり、大きな社会貢献に繋がります。
▼この削減量は1世帯当たりのCO2年間排出量が
1,500kg(電力使用量相当)ですので
⇒ 概ね1,300世帯分の年間排出量削減に相当します。
ハニカムの清掃時間を劇的に短縮します
従来の清掃方法
1
ハニカムの取り外し
2
洗い場まで運搬
3
洗剤による洗浄
4
流水による洗い流し
5
ハニカムの乾燥
6
ハニカムの取り付け
● 9尺ケース(幅270cm)
● ハニカム6本
● 作業員 3人で
所要時間:約60分/1台
▶
ハニカム防塵シート交換
による方法
1
ハニカムの取り外し
2
その場で防塵シートを取り外し
新しいシートを装着
3
ハニカムの取り付け
● 9尺ケース(幅270cm)
● ハニカム6本
● 作業員 1人で
所要時間:約10分/1台
ハニカム防塵シート・1店舗の費用/1ヶ月
業種別の標準的な店舗での費用イメージ/1ヶ月です。
スーパーマーケット・生協

11,000円/月
冷蔵ショーケース:50台
防塵シート:ロールタイプ
ドラッグストア
1,600円/月
冷蔵ショーケース:6台
防塵シート:シートタイプ
コンビニエンスストア

550円/月
冷蔵ショーケース:3台
防塵シート:シートタイプ
● ハニカム防塵シートの費用目安であり、清掃、設置、交換作業費等は含まれていません。
防塵・省エネ・簡単設置のトリプル効果で、
不衛生状態の改善に貢献します!!
CONTACT
冷蔵ショーケースの「清掃・カビ対策」を、もっと簡単に。
清掃し続けるしかなかった冷蔵ショーケースのカビ対策を、
「設置するだけ」の新しい方法へ。
ハニカム防塵シートが、清潔で安心な売場づくりを支えます。

